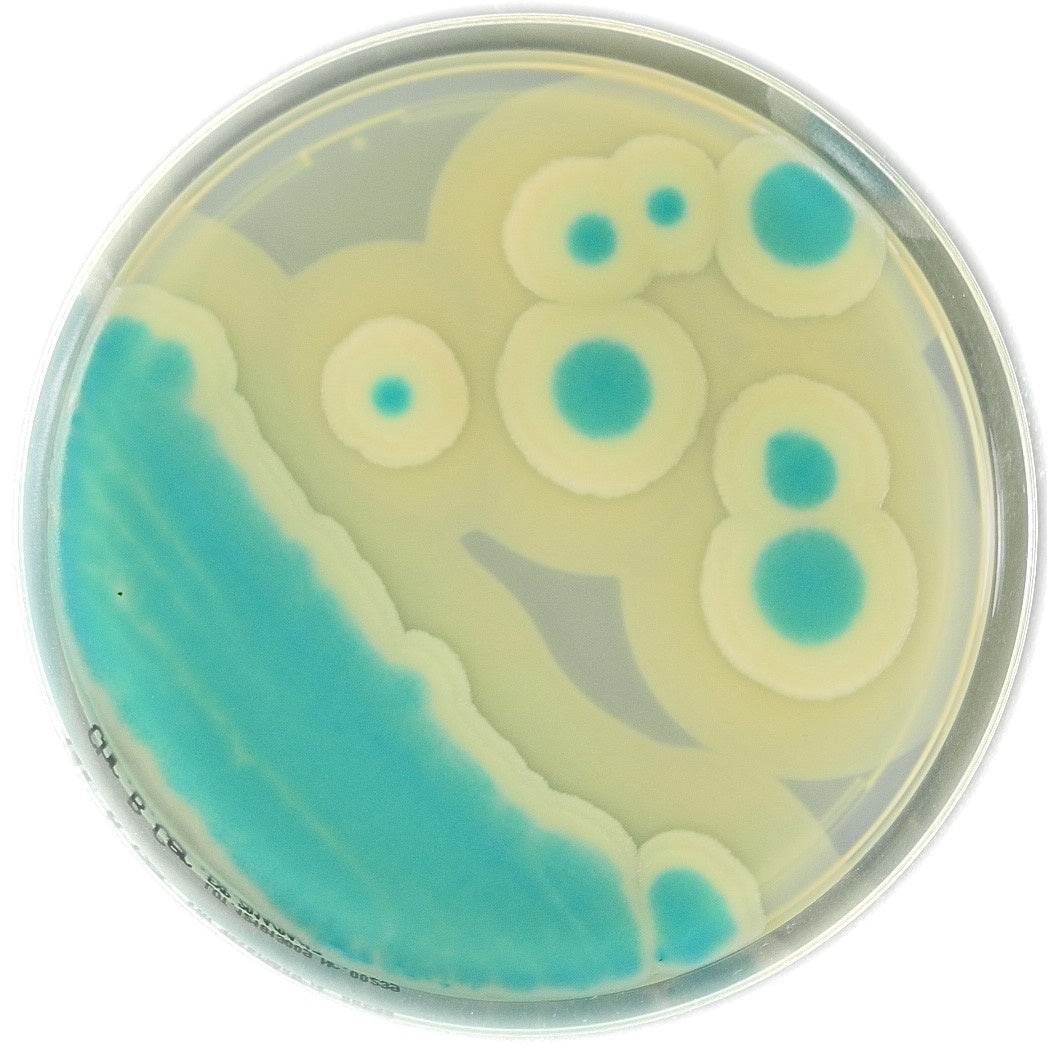

All Products
Showing 1273 - 1296 of 1448 products
Display
View
Liofilchem
Listeria Demi Fraser Broth 3 L bag 3/pack - For Microbiology Lab Testing
Sale price$483.00 CAD
Liofilchem
Listeria Demi Fraser Broth 5 L bag 3/pack - For Microbiology Lab Testing
Sale price$644.00 CAD
Liofilchem
Listeria UVM MOD Broth 3 L bag 3/pack - For Microbiology Lab Testing
Sale price$644.00 CAD
Liofilchem
Listeria UVM MOD Broth 5 L bag x 3/pack - For Microbiology Lab Testing
Sale price$859.00 CAD


Liofilchem
Bismuth Sulphite Agar ISO 6579-1 - For Microbiology Lab Testing
Sale priceFrom $107.00 CAD
Filters (0)